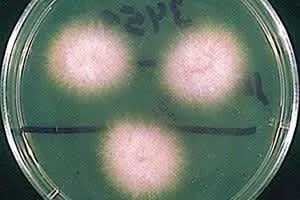

Fusarium Oxysporum
| Use attributes for filter ! | |
| Kingdom | Fungi |
|---|---|
| Class | Sordariomycetes |
| Order | Hypocreales |
| Scientific name | Fusarium oxysporum |
| Rank | Species |
| Did you know | F. oxysporum is a major wilt pathogen of many economically important crop plants. |
| Date of Reg. | |
| Date of Upd. | |
| ID | 1177736 |
About Fusarium Oxysporum
Fusarium oxysporum pronounce, an ascomycete fungus, comprises all the species, varieties and forms recognized by Wollenweber and Reinking within an infrageneric grouping called section Elegans. It is part of the Nectriaceae family.